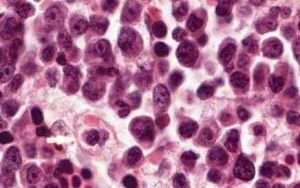
噬血細胞綜合徵

病因
噬血細胞綜合徵主要分為原發性(遺傳性)及繼發性。前者為常染色體隱性遺傳或X連鎖遺傳,存在明確基因缺陷或家族史。後者可由感染(主要為EB病毒感染)、惡性腫瘤、自身免疫性疾病、藥物、獲得性免疫缺陷(如移植)等多種因素引起。
臨床表現
1.家族性噬血細胞綜合徵
發病年齡一般較早,多數發生於1歲以內,但亦有年長發病者。臨床表現多樣,早期多為發熱、肝脾腫大,亦可有皮疹、淋巴結腫大及神經症狀。發熱多為持續性,亦可自行熱退。肝脾腫大明顯。皮疹無特徵性,多為一過性。約半數患者可有淋巴結腫大,明顯腫大者應與淋巴瘤鑑別。中樞神經系統受累多發生於晚期,可有興奮性增高、前囟飽滿、肌張力改變及抽搐,亦可有局部神經系統體徵。肺部可為淋巴細胞或巨噬細胞浸潤,與感染鑑別較困難。常見的死因為出血、感染、多臟器功能衰竭及DIC等。
2.繼發性噬血細胞綜合徵
(1)感染相關性噬血細胞綜合徵嚴重感染可引起強烈的免疫反應,多發生於免疫缺陷患者。常由病毒引起,但細菌、真菌、立克次體及原蟲感染亦可引起。其臨床表現為噬血細胞綜合徵的表現外還存在感染的證據。
(2)腫瘤相關性噬血細胞綜合徵急性白血病、淋巴瘤、精原細胞瘤等可在治療前、中、後並發或繼發噬血細胞綜合徵。由於原發病可能較為隱匿,特別是淋巴瘤患者,故極易將其誤診為感染相關性噬血細胞綜合徵。
(3)巨噬細胞活化綜合徵是兒童慢性風濕性疾病的嚴重併發症,多見於系統性青少年型類風濕性關節炎患者。在慢性風濕性疾病的基礎上,患者出現發熱、肝脾腫大、全血細胞減少、肝功能異常及中樞神經系統病變等噬血細胞綜合徵的表現。
檢查
1.血常規
多為全血細胞減少,血小板減少較為明顯。
2.生化檢測
早期可出現甘油三酯升高,轉氨酶及膽紅素亦可升高。常見高密度脂蛋白膽固醇降低,低密度脂蛋白膽固醇及極低密度脂蛋白膽固醇降低,病情緩解時可恢復。乳酸脫氫酶常常升高,極度增高者需除外血液/淋巴系統腫瘤。血清鐵蛋白可明顯升高,可作為診斷及監測病情的手段。
3.骨髓檢查
骨髓塗片可見到噬血現象,早期噬血現象不明顯,多次骨髓塗片有助於發現噬血現象。此外還應行骨髓活檢術,進行骨髓病理檢查以除外血液/淋巴系統腫瘤。
4.凝血功能
疾病活動時常存在凝血功能障礙,治療有效凝血功能恢復。可發現凝血酶原時間及部分凝血活酶時間可延長,纖維蛋白原可明顯降低,D-二聚體可升高。
5.免疫學檢查
可出現NK細胞數量及功能的降低,細胞因子可溶性CD25、IFN-γ、TNF增多。
6.影像學檢查
胸片可見肺浸潤,頭顱CT及MRI可見異常如腦白質異常、脫髓鞘改變、出血、萎縮或水腫等。
7.腦脊液
細胞中度增多,一般為5~50×10/L,主要為淋巴細胞。腦脊液蛋白增高、糖降低。部分患者有神經系統症狀,但腦脊液未見異常。
診斷
目前缺乏特異性診斷方法。現廣泛使用國際組織細胞協會制定的2004年診斷標準,滿足以下2條之一便可建立HLH診斷:
噬血細胞綜合徵
噬血細胞綜合徵PRF1、UNC13D、Munc18-2、Rab27a、STX11、SH2D1A或BIRC4等基因突變;
2.滿足以下8條中的5條診斷標準
①發熱;
②脾大;
③血細胞減少(影響2或3系外周血細胞):血紅蛋白<90g/L(新生兒:血紅蛋白<100g/L),血小板<100×10/L,中性粒細胞<1.0×10/L;
④高三醯甘油血症和(或)低纖維蛋白原血症:空腹甘油三酯≥3.0mmol/L(≥2.65g/L),纖維蛋白原≤1.5g/L;
⑤骨髓、脾或淋巴結中發現噬血細胞現象而非惡變證據;
⑥NK細胞活性減低或缺乏(根據當地實驗室指標);
⑦鐵蛋白≥500μg/L;
⑧可溶性CD25(sIL-2R)≥2400U/mL。
鑑別診斷
首先必須區分先天性亦或是繼發性,特別是將前者與病毒相關性噬血細胞綜合徵相區分。其次必須嚴格除外腫瘤相關性噬血細胞綜合徵。由於本病具有階段性,早期患者可不表現出所有特徵,導致早期診斷困難,可多次複查骨髓或是反覆進行相關檢查可有利於早期診斷。
治療
家族性噬血細胞綜合徵預後差,疾病進展迅速,建議儘早行骨髓移植術。繼發性噬血細胞綜合徵的治療較為複雜。一方面必須針對原發疾病治療,例如血液/淋巴系統腫瘤需行化療,感染相關噬血細胞綜合徵需抗感染治療。在原發病治療的同時應使用噬血細胞綜合徵治療方案來控制病情的發展。目前國際上普遍採用HLH-2004方案治療繼發性噬血細胞綜合徵。2004方案以地塞米松、依託泊苷及環孢黴素為基礎,分為前8周的初始治療期及維持治療期,另外加以鞘內注射。急性期使用丙種球蛋白有助於緩解病情。
如果治療困難、失敗或疾病復發,可考慮行骨髓移植術。

